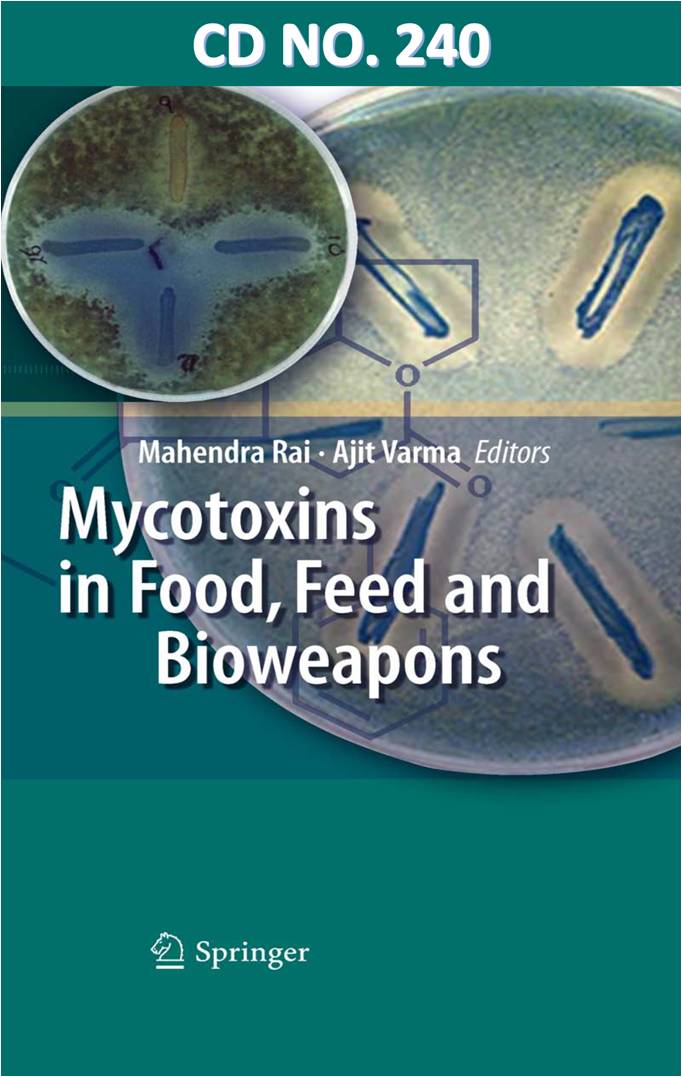

| Judul | MYCOTOXINS in food, Feed and bioweapons / John Janovy |
| Pengarang | Edited by Mahendra Rai Ajit Varma |
| EDISI | Seventh edition |
| Penerbitan | Berlin : Bentham Springer, 2010 |
| Deskripsi Fisik | 1 file; 5,73 MB (CD NO 240) |
| ISBN | 978-3-642-00725-5 |
| Subjek | MYCOTOXINS -- FEEDS -- FOODS |
| Catatan | CD No. 240; Dis. no.7 (2015) |
| Bahasa | Tidak tersedia |
| Bentuk Karya | Tidak ada kode yang sesuai |
| Target Pembaca | Tidak ada kode yang sesuai |
| No Barcode | No. Panggil | Akses | Lokasi | Ketersediaan |
|---|---|---|---|---|
| 095BPV2015 | e615.9/MYC6 | Dapat dipinjam | Perpustakaan Balai Besar Perakitan dan Modernisasi Veteriner - Koleksi EBook | Tersedia |
| Tag | Ind1 | Ind2 | Isi |
| 001 | INLIS000000000014473 | ||
| 005 | 20240326115414 | ||
| 008 | 240326################|##########|###### | ||
| 020 | # | # | $a 978-3-642-00725-5 |
| 035 | # | # | $a 0010-0521014473 |
| 041 | $a en | ||
| 082 | # | # | $a 615.9 |
| 090 | $a e615.9/MYC6 | ||
| 100 | 0 | # | $a Edited by Mahendra Rai |
| 245 | 1 | # | $a MYCOTOXINS in food, Feed and bioweapons /$c John Janovy |
| 250 | # | # | $a Seventh edition |
| 260 | # | # | $a Berlin :$b Bentham Springer,$c 2010 |
| 300 | # | # | $a 1 file; 5,73 MB (CD NO 240) |
| 500 | # | # | $a CD No. 240; Dis. no.7 (2015) |
| 650 | 4 | $a MYCOTOXINS -- FEEDS -- FOODS | |
| 700 | 0 | # | $a Ajit Varma |
| 990 | # | # | $a 95/BPV/2015 |
Content Unduh katalog
Karya Terkait :